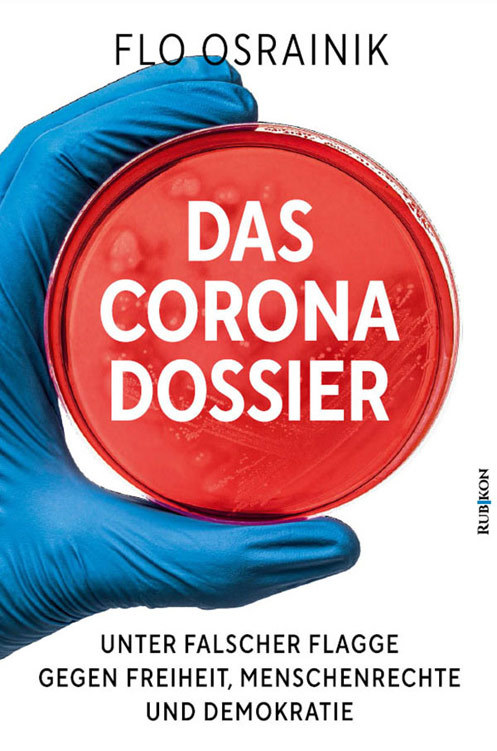

~20 MB – pdf

11.27 MB – pdf
Beschreibung:
John F. Kennedy war für uns ein lebendiger Traum. Er war derjenige, der Große Teile Amerikas spaltete sie andererseits zusammenführte. Sein Leben war geprägt von außerordentlicher Zivilcourage. Nicht nur für die Gemeinschaft sondern auch für sich selbst. Das Streben nach Macht und Einfluss wurde zum Leitmotiv der amerikanischen Kennedy-Familie. Erst der Mut, der eine Persönlichkeit bestimmt drängt sie an die Grenzen ihres Könnens. Ein Mut, der nicht für mich, sondern für die anderen zur Hingebung wird. Wie John F. Kennedy zu sagen pflegte “Fragt nicht was euer Land für euch tun kann – Fragt was ihr für euer Land tun könnt” war nicht nur in den 60er Jahren aktuelle. Nein vielemehr dominiert dieses Zitat das gesellschaftliche Fehlverhalten, in das wir hineingewachsen sind. Robert F. Kennedy wollte immer das erreichen, was seinem Bruder als einzigem vorenthalten blieb. Die absolute Verehrung einer ganzen Generation. Aus Hass zu dieser Hingabe, wurden sowohl “Bobby” als auch “Jack” auf grausame Weise ermordet. Doch waren ihre Lebenswerke bis zur letzten Sekunde von Mut geprägt.

0.50 MB – epub
Beschreibung:
Top 3 vom Seraph Phantastik Preis 2018 als »Bester Independent Titel«
Prag, 1620: Krieg, Hunger und ein Geist mit dem Namen »Rumpelstilzchen« suchen die Stadt heim.
Wo immer er erscheint, verschwindet ein Kind.
Alene, die die Gabe besitzt, die Geister der Toten zu sehen, ist ihm bereits vor einem Jahr begegnet. Nun ist sie selbst schwanger.
Gequält von der Angst, ihr Kind verlieren zu können, schlägt sie sich im zerrütteten Prag durch.
Aber sie scheint nur ein Spielball höherer Mächte zu sein: Wieso tritt ihr lang verlorener Kindheitsfreund Patrik Emil wieder in ihr Leben? Warum will er sie zum König von Prag bringen?
Alene muss nach Antworten suchen … doch ihr bleiben nur drei Tage. Denn Rumpelstilzchen hat ihren Tod prophezeit.
Eine dunkelfantastische Thriller-Adaption zur Zeit des 30-jährigen Krieges, angelehnt an das bekannte Märchen der Brüder Grimm: »Rumpelstilzchen«.
Bereits in der »Galgenmärchen«-Reihe erschienen:
Wolfssucht (Novelle, Mai 2016)
Kindsräuber (Roman, März 2017)
Bärenbrut (Kurzgeschichte, Juli 2017)
Hexensold (Roman, November 2018)
Alle Teile der Reihe sind lose miteinander verbunden, können aber unabhängig voneinander gelesen werden.
0.87 MB – epub
Beschreibung:
Top 3 vom Seraph Phantastik Preis 2019 als »Bester Independent Titel«
[b]»Tanze nicht mit Feen und handle nie mit Hexen.«[/b]
Elegio kennt diese Warnung, seit er ein kleiner Junge ist.
Geboren in eine Familie von Assassinen wächst er im Oberitalien des 17. Jahrhunderts auf. Sein Vater Lysander setzt alles daran, ihn auszubilden. Doch dem sanften Elegio ist Töten zuwider.
Sein Leben ändert sich für immer, als er in den Besitz eines verzauberten Kleides gelangt. Es verwandelt ihn in Rapunzel – eine gefährliche Schönheit. In ihrer Gestalt ist er endlich der Todesengel, den Lysander in ihm sehen will.
*
[b]Aber sein Vater hat ihn nicht grundlos vor Hexenwerk gewarnt. Mit Rapunzel erwachen Mächte im Land, die einen nie dagewesenen Krieg entfesseln.[/b]
[list]
[*]
[/list]
Und Elegio, der nie kämpfen wollte, gerät mitten zwischen die Fronten …
[b]Eine dunkelfantastische Thriller-Adaption zur Zeit des 30-jährigen Krieges, angelehnt an das bekannte Märchen der Brüder Grimm: »Rapunzel«.[/b]
Bereits in der »Galgenmärchen«-Reihe erschienen:
[b]Wolfssucht[/b] (Novelle, Mai 2016)
[b]Kindsräuber[/b] (Roman, März 2017)
[b]Bärenbrut[/b] (Kurzgeschichte, Juli 2017)
[b]Hexensold[/b] (Roman, November 2018)
Alle Teile der Reihe sind lose miteinander verbunden, können aber unabhängig voneinander gelesen werden. **

8.87 MB – pdf
Beschreibung:
Angst gefährdet die Gesundheit. Wissen stärkt die Abwehrkräfte ― gegen Viren, gefährliche Propaganda und Lügen. Bereits bei Schweine- und Vogelgrippe versuchten Pharmakonzerne und Virologen mit falschen Pandemie-Alarmen Millionen Menschen in die Irre zu führen. Der Arzt, Politiker und ehemalige Bundestagsabgeordnete Wolfgang Wodarg vereitelte diese Pläne damals maßgeblich und bezieht auch heute wieder unmissverständlich Position: »Wir erleben zurzeit ein immenses Verbrechen gegen die Menschheit. Offenkundig treibt die Corona-Profiteure nicht die Sorge um die Umwelt und unsere Gesundheit, nicht die Emanzipation oder der Schutz vor Erderwärmung an. Ihre Triebkraft ist, wie schon lange vorher, ihre kranke Gier nach Reichtum, Monopolen und Macht.«
Wolfgang Wodarg entlarvt die Pandemie als Putsch von oben, gesteuert von Impfmafia und Techno-Elite. Sein Buch ist ein unentbehrlicher Wegweiser ― zu wahrer Solidarität, wirklicher Demokratie sowie einem Gesundheitswesen, das nicht kranken Kapitalinteressen, sondern Menschen dient.

4 MB – epub
Beschreibung:
Eine Reise in die Vergangenheit für Privatermittler Nik Pohl von Bestsellerautor Alexander Hartung.
Beim Ausheben eines Grabs wird die Leiche von Rachel Preuss gefunden, sechs Jahre nach ihrem Verschwinden. Für Nik Pohl ist es wie eine Reise in die Vergangenheit. Zu seiner aktiven Zeit bei der Kripo war er als Einziger davon überzeugt, dass sie einem Verbrechen zum Opfer gefallen war. Er beschafft sich die neusten Informationen der Kripo, ist er doch fest entschlossen, den Mörder dieses Mal zu finden.
Nach Tagen pausenloser Ermittlungen gibt es immer noch keine neue Spur zum Täter. Dann stoßen Nik und sein Team auf den ebenfalls länger zurückliegenden Fall einer Frau, die sich auf den Weg in den Urlaub gemacht hat und nie wieder aufgetaucht ist …

13,3 MB – epub, mobi, azw3
Beschreibung:
Nach jahrelanger vordergründig glücklicher Ehe mit der attraktiven und wohlhabenden Marie-Lore verliebt sich Jurist Pierre André in Simona, eine jüngere Journalistin. Eine Scheidung ist unumgänglich. Marie-Lore bemüht sich, nach aussen hin die verständnisvolle Ehefrau zu spielen. Ih ihrem Innersten braut sich jedoch ein verhängnisvoll vernichtender Plan zusammen.

2.43 MB – epub
Beschreibung:
Sophies Leben ist überhaupt nicht so, wie sie es sich mal ausgemalt hat. Ihr Job als Assistentin bei einem Hamburger Filmverleih nervt extrem, mit ihrem Freund läuft es auch nicht mehr rund, und ihr Traum von einer Karriere als Köchin scheint in weite Ferne gerückt zu sein. Als sie aus Versehen die Marketingleitung für den neuesten Blockbuster-Film an der Nordsee übernehmen soll, ist sie komplett überrumpelt und sagt zu. Für Sophie ist ihr Aufenthalt am Meer damit eigentlich schon turbulent genug, aber das Schicksal legt noch eine Schippe drauf. Während der Dreharbeiten der romantischen Komödie in den Dünen Dänemarks lernt sie einen attraktiven Unbekannten und dessen Hund kennen – und vergisst dabei ganz, dass sie zu Hause ja eigentlich schon liiert ist …

2,3 MB – epub, mobi, azw3
Beschreibung:
Die Macht von Stonehenge ist 5000 Jahre alt. Sie ist kein Mythos. sie lebt. Und sie ist tödlich.
Acht Tage vor der Sommersonnenwende stirbt in Stonehenge ein Mann bei einem grausamen Opferritual. Kann der junge Archäologe Gideon verhindern, dass am “Tag des Blutes” die uralten Kräfte des Steinkreises erwachen?
0.60 MB – epub
Beschreibung:
Corona hier, Corona da, Corona überall. Seit nunmehr einem Jahr kennt die Politik kein anderes Thema mehr und verbreiten die Massenmedien gezielt Angst und Schrecken, um die Menschen im Dauerstress zu halten und die Entscheidungen der Mächtigen als alternativlos erscheinen zu lassen. Doch geht es wirklich um ein Virus? Ein Jahr nach Beginn der Krise fängt der Spuk erst richtig an: Die Welt wird im Sinne weniger Regenten neu geordnet, ihre Macht weiter konzentriert. Der Klassenkrieg von Reich gegen Arm eskaliert und die Verschmelzung von Staat und Technokratie ist in vollem Gange. Corona dient dabei nur als Vorwand, das staatliche Gewaltmonopol gegen Menschen und Menschenrechte in Stellung zu bringen und alles niederzuwalzen und unterdrücken, was sich totaler Kontrolle nicht freiwillig unterwirft. Anders als vordergründig beteuert, geht es dabei nicht um das Wohl der Vielen, die Ausrottung von systembedingter Armut und Krieg, sondern um die Errichtung eines digitalen Totalitarismus, der als internationaler Faschismus das Licht der Welt erblickt. Doch noch ist es nicht zu spät zu handeln.
Flo Osrainik skizziert Vorgeschichte und Hintergründe der Pandemie und nennt diejenigen beim Namen, die hinter den Kulissen längst die Gangart der globalen Politik bestimmen. Er enthüllt einen Plan, der seit Jahrzehnten vorbereitet wurde, und offenbart, worum es bei den aktuellen Entwicklungen tatsächlich geht.


